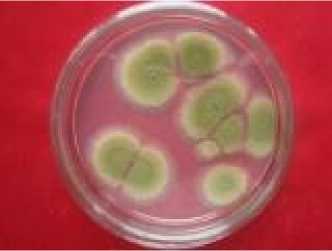
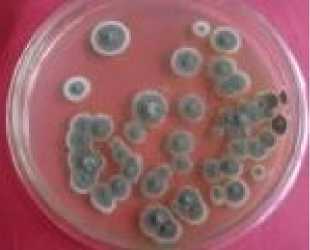
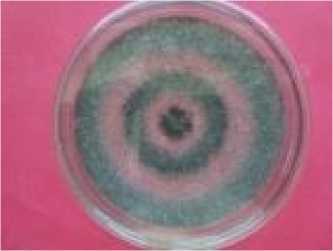

DAYA HAMBAT EKSTRAK KASAR DAUN KALIANDRA (Calliandra calothyrsus Meissn.) TERHADAP JAMUR KONTAMINAN PADA PAKAN KONSENTRAT AYAM RAS PEDAGING
on
JURNAL SIMBIOSIS IV (2): 31-38
Jurusan Biologi FMIPA Universitas Udayana
I SSN: 2337-7224
September 2016
http://ojs.unud.ac.id/index.php/simbiosis
ΓΛ<" Λ Directoryof
OPEN ACCESS
JOURNALS
DAYA HAMBAT EKSTRAK KASAR DAUN KALIANDRA (Calliandra calothyrsus Meissn.) TERHADAP JAMUR KONTAMINAN PADA PAKAN KONSENTRAT AYAM RAS PEDAGING
INHIBITION OF CALLIANDRA (Calliandra calothyrsus Meissn.) CRUDE EXTRACT LEAF ON MUSHROOMS CONTAMINANTS ON FEED CONCENTRATE BROILER
I Gede Sugita Artana, IB.G Darmayasa, Meitini W. Proborini Jurusan Biologi, Fakultas Matematika dan Ilmu Pengetahuan Alam Kampus Bukit Jimbaran, Universitas Udayana baltimicrobiology@gmail.com
INTISARI
Penelitian ini bertujuan untuk mengetahui jenis-jenis jamur yang mengkontaminasi pakan konsentrat ayam ras pedaging dan mengetahui daya hambat ekstrak kasar daun kaliandra terhadap jamur kontaminan. Pengambilan sampel pakan konsentrat dan daun kaliandra dilakukan di Kecamatan Selat Kabupaten Karangasem Bali. Untuk mendapatkan ekstrak kasar daun kaliandra maka digunakan metode pengenceran sedangkan untuk mengetahui daya hambat ekstrak kasar daun kaliandra dengan menggunakan metode sumur difusi. Hasil penelitian menunjukkan ditemukan enam jenis jamur pada sampel pakan konsentrat ayam pedaging yaitu Aspergilus flavus, Aspergillus niger, Aspergillus fumigatus, Penicillium brevicompactum, Penicillium candidum dan Trichoderma viridae. Hasil penelitian menunjukkan bahwa secara in vitro ekstrak kasar daun kaliandra dapat menghambat pertumbuhan jamur Aspergillus flavus pada konsentrasi ekstrak 100.000 ppm dengan rata-rata zona hambat sebesar 12,72 ± 0,27 mm.
Kata kunci: jamur, daya hambat, ekstrak kasar, daun kaliandra, Aspergillus flavus
ABSTRACT
This aims of the study were to determine the species of fungi contaminated chicken broiler consentrate and to find out the inhibition of crude extract's leaves of caliandra. The samples were taken in Selat, Karangasem. Maceration method was conducted to extracted leaves of caliandra, disk diffusion agar method was conducted to find out the inhibition of crude extract leaves of caliandra. Result showed that there were six types of fungi on chichken broiler consentrate such as Aspergilus flavus, Aspergilus niger, Aspergillus fumigatus, Penicillium brevicompactum, Penicillium candidum dan Trichoderma viridae. The result also showed that 100.000 ppm extract concentrate inhibit Aspergillus flavus growth on 12.72 ± 0,27 mm.
Keywords : fungi, inhibition strength, crude extract’s, caliandra, Aspergillus flavus
PENDAHULUAN
Pakan merupakan salah satu faktor strategis yang dapat mempengaruhi produktivitas ternak. Biaya pakan menempati porsi paling besar dari keseluruhan total biaya produksi yaitu 70 - 80%, sehingga dalam memproduksi pakan bukan hanya harus baik secara kualitas, tetapi harga juga perlu terjangkau oleh para peternak unggas (Deptan, 2012). Usaha pengembangan peternakan di Indonesia banyak mengalami kendala, antara lain kualitas pakan yang banyak menimbulkan masalah penyakit, terutama mikotoksikosis (Hastiono, 1983; Marquerita et al., 1990; Handayani dan Sulistyo, 2000).
Kasus mikotoksikosis masih menjadi salah satu kasus yang penting di peternakan Indonesia (Infovet, 2010; Infomedion, 2011; Ritonga, 2008). Pemberian pakan yang terkontaminasi mikotoksin pada ayam ras pedaging dapat menimbulkan gangguan kesehatan serius meliputi gejala keracunan hingga pada kematian (Achmadi, 1998). Kasus yang sering terjadi di lapangan dapat berdampak signifikan menekan produksi ternak ayam walaupun jarang sampai menimbulkan kematian. Peternak pasti rugi jika manajemen penanganan pakan tidak tepat. Majalah Infovet (2008) menambahkan bahwa jamur pada musim penghujan sangat mudah tumbuh dan berbiak di semua tempat termasuk pada pakan yang dapat menyebabkan mikotoksikosis, pertumbuhan terhambat, masa produksi lambat umur, secara patologi anatomi terjadi malabsorpsi, rusaknya usus, pankreas, terjadinya proventrikulus yang pada akhirnya menyebabkan kekerdilan.
Penggunaan bahan-bahan kimia sintetis dapat digunakan untuk mengendalikan jamur kontaminan namun residu yang ditinggalkan dapat berbahaya bagi ternak ataupun manusia. Oleh karena itu penggunaan bahan nabati sangat diperlukan untuk meminimalisasi dampak dari penggunaan bahan-bahan sintetis tersebut. Salah satu tanaman penghasil zat metabolit sekunder yang dapat dimanfaatkan sebagai pengendali serangan jamur pencemar adalah ekstrak kasar daun Kaliandra (Calliandra calothyrsus Meissn.).
Tanaman kaliandra merupakan tanaman yang dikenal sebagai hijauan pakan ternak ruminansia karena tangkai, bunga dan daunnya mempunyai kandungan protein yang cukup tinggi dan sangat bermanfaat bagi peningkatan produktivitas ternak (Mannetje dan Jones, 1992; Tangendjaja et al., 1992). Selain kandungan protein, berdasarkan penelitian Tim Laboratorium INTP Fakultas Peternakan IPB Bogor (2007) terdapat 11% tanin. Tanin dapat berikatan dengan dinding sel mikroorganisme dan mampu menghambat pertumbuhan mikroorganisme atau menghambat aktivitas enzim (Smith et al., 2005).
Berdasarkan uraian di atas perlu dilakukan penelitian untuk mengisolasi dan mengidentifikasi jenis jamur yang berpotensi sebagai pencemar pada pakan konsentrat ayam ras pedaging yang diperoleh dari beberapa lokasi peternakan dan distributor di Kecamatan Selat, Kabupaten Karangasem, Provinsi Bali. Sehingga pada akhirnya diharapkan ekstrak daun kaliandra mampu menekan pertumbuhan jamur pencemar pada pakan konsentrat.
MATERI DAN METODE
Identifikasi Jamur
Isolasi jamur dilakukan dengan metode pengenceran, sebanyak 10 gram sampel dimasukkan ke dalam larutan pengencer aquades steril 90 ml lalu dikocok sehingga diperoleh pengenceran 10-1. Metode yang sama dilakukan untuk pengenceran 10-2 - 10-5. Diambil 1 ml sampel (bahan pengencer 10-4 - 10-5) dengan pipet steril, kemudian ditanam pada media PDA dalam cawan petri. Sampel diinkubasi pada suhu ruang selama 2 - 7 hari. Koloni jamur yang tumbuh direisolasi pada media PDA untuk dilakukan identifikasi jamur (Proborini, 2002). Identifikasi jamur dilakukan dengan pengamatan secara makroskopis dan mikroskopis. Literatur yang digunakan untuk mengidentifikasi jamur diantaranya menurut Pitt and Hocking (1997) dan Ganjar dkk., (1999).
Directoryof OPEN ACCESS JOURNALS
Pembuatan Ekstrak Kasar
Pembuatan ekstrak kasar daun kaliandra menggunakan metode maserasi. Daun dikeringanginkan, diblender sampai menjadi bentuk tepung, kemudian ditimbang sebanyak 200 gram, dimaserasi dengan 1 liter methanol selama 72 jam pada suhu kamar. Selanjutnya dilakukan penyaringan dengan menggunakan kain kasa. Filtrat yang diperoleh melalui penyaringan diuapkan dengan vacum rotary evaporator pada suhu 400 C untuk memisahkan solvent dan ekstrak. Ekstrak yang terbentuk diencerkan dengan methanol sesuai dengan konsentrasi yang diinginkan yaitu 100 ppm, 1.000 ppm, 10.000 ppm, dan 100.000 ppm (Tunjung et al., 2001).
Uji Daya Hambat
Uji daya hambat dilakukan dengan metode difusi agar. Disiapkan cawan petri steril yang telah diisi suspensi jamur uji sebanyak 1 ml, lalu dituangkan sebanyak 15 ml media PDA dalam kondisi cair (suhu 400 C - 450 C), digoyang secara simultan agar pertumbuhan jamur terjadi secara merata dan dibiarkan hingga membeku. Setelah padat media PDA steril dibuat dua lubang (sumur) secara aseptis dengan diameter 5 mm, dimasukkan ekstrak kasar daun kaliandra sebanyak 60 - 80 µL dengan masing-masing konsentrasi 100 ppm; 1.000 ppm; 10.000 ppm; dan 100.000 ppm, dan kontrol digunakan methanol, kemudian diinkubasi pada suhu ruang selama 24 sampai 48 jam. Aktivitas daya hambatnya ditentukan berdasarkan diameter zona hambat yang terbentuk di sekitar kertas cakram. Zona penghambatan merupakan areal bening yang muncul di sekeliling sumur
diamati dan diukur dengan jangka sorong. Setiap zona bening diukur diameternya sebanyak tiga kali di tempat berbeda dan hasilnya dirata-ratakan. Data dianalisis secara kuantitatif dengan menghitung total koloni jamur pada tiap-tiap sampel, dan menghitung besarnya zona hambat yang terbentuk dari pengaruh ekstrak kasar daun kaliandra terhadap jamur kontaminan yang mencemari pakan konsentrat ayam ras pedaging dengan menggunakan Analysis Of Variance (ANOVA) dan dilanjutkan dengan uji Duncan Multiple Range Test taraf signifikansi 5%.
HASIL DAN PEMBAHASAN
HASIL
Berdasarkan hasil pengamatan didapatkan koloni jamur yang tumbuh pada media PDA dan hasil identifikasi secara makroskopis maupun mikroskopis ditemukan enam spesies jamur yaitu Aspergilus flavus, Aspergillus niger, Aspergillus fumigatus, Penicillium brevicompactum, Penicillium candidum dan Trichoderma viridae.
Koloni secara makroskopis umur 4 (empat) hari pada media PDA dengan diameter 1,5 cm, berwarna hijau kekuningan dengan warna sebalik koloni berwarna putih atau kuning keabuan, tidak terdapat eksudat dan terdapat garis-garis radial. Secara mikroskopis konidia khas berbentuk bulat, berukuran 2,5 µm dan berwarna hijau kekuningan hingga hijau tua kekuningan, konidiofor kasar, fialid terbentuk langsung pada metula.
1
3
2
4
A B
Gambar 1. Aspergillus flavus (A) Makroskopis, (B) Mikroskopis;
(1) Konidia, (2) Sterigma, (3) Vesikel, dan (4) Konidiofor

A B
Gambar 2. Aspergillus niger (A) Makroskopis, (B) Mikroskopis; (1) Konidia,
(2) Sterigma, (3) Vesikel, dan (4) Konidiofor
Secara makroskopis jamur ini memiliki ciri-ciri warna koloni awal putih seperti beludru, setelah 3 (tiga) hari pertumbuhannya pada media PDA dengan diameter 4 - 5 cm terdapat spora berwarna hitam semakin tua umur koloni tersebut semakin banyak spora sehingga koloni berwarna hitam dengan warna sebalik koloni abu-abu, membentuk garis-garis radier, tidak menghasilkan eksudat. Secara
mikroskopis jamur ini memiliki sel kaki (foot cell) yang berasal dari hifa yang menegak, hifa berseptat, ujung dari hifa yang menegak kemudian menggelembung membentuk vesikel, terdapat sterigma, pada ujung sterigma terdapat konidia, konidia berbentuk bulat seperti bola berukuran 3,5 µm.
Directoryof OPEN ACCESS JOURNALS

A B
Gambar 3. Aspergillus fumigatus (A) Makroskopis, (B) Mikroskopis; (1) Konidiofor, (2) Vesikel, (3) Fialid, dan (4) Konidia
Koloni saat muda berwarna putih dan dengan cepat berubah menjadi hijau seiring dengan terbentuknya konidia. Koloni secara makroskopis umur 4 (empat) hari pada media PDA mencapai diameter 3 - 5 cm warna permukaan koloni hijau tua. Secara mikroskopis jamur ini memiliki kepala
konidia berbentuk kolumnar, konidiofor pendek, berdinding halus, berwarna hijau. Vesikula berbentuk gada, berwarna hijau. Konidia bulat sampai semi bulat, berwarna hijau dan berdinding kasar. Konidiofor tumbuh lebat yang terbentuk dari miselia yang ada di agar juga dari miselium aerial.
A

B
Gambar 4. Penicillium brevicompactum (A) Makroskopis, (B) Mikrokopis; (1) Konidia, (2) Fialid, (3) Metula, dan (4) Konidiofor
Secara makroskopis koloni tumbuh 4 - 6 hari pada media PDA dengan diameter mencapai 1 cm, berwarna hijau tua dengan warna sebalik koloni hijau kuning kecoklatan, biasanya koloni tumbuh menyebar dan
memenuhi cawan petri. Secara mikroskopis jamur ini memiliki ciri-ciri konidia bulat, berukuran 2,5 - 3,75 µm, fialid berbentuk botol, konidiofor berdinding halus.

A

Gambar 5. Penicillium candidum (A) Makroskopis, (B) Mikroskopis;
(1) Konidia, (2) Fialid, (3) Metula, dan (4) Konidiofor
Pengamatan secara makroskopis koloni pada umur 4 (empat) hari diameter mencapai 2,5 - 3 cm, miselium berwarna putih, sebalik koloni putih kekuningan dan terdapat eksudat berwarna putih. Secara mikroskopis
konidiofor berasal dari hifa aerial, mempunyai dinding halus, pada ujung terdapat terminal biverticiliate atau quarterverticiliate, konidia mempunyai dinding halus.

1
2
3
A B
Gambar 6. Trichoderma viridae (A) Makroskopis, (B) Mikroskopis;
(1) Konidia, (2) Fialid, dan (3) Konidiofor
Secara makroskopis, koloni mula-mula seperti velvet, halus dan berwarna putih, kemudian menjadi berwarna hijau tua dengan tepi berwarna putih, sebalik koloni berwarna hijau kekuningan. Secara mikroskopis
jamur ini memiliki konidofor bercabang menyerupai piramida, tidak teratur, fialid berbentuk seperti botol dan berkelompok. Konidia berwarna hijau hingga biru,

dindingnya halus dan dibentuk di dalam kepala konidia yang terikat di ujung fialid.
Tabel 1. Jenis dan jumlah jamur yang ditemukan pada lima sampel
No |
Jenis Jamur |
PT 1 |
PT 2 |
Sampel PT 3 DT 1 |
DT 2 |
Total |
1 |
Aspergillus flavus |
1202 |
399 |
47 234 |
189 |
2071 |
2 |
Aspergillus niger |
9 |
2 |
2 - |
- |
13 |
3 |
Aspergillus fumigatus |
18 |
- |
- - |
- |
18 |
4 |
Penicillium brevicompactum |
1 |
1 |
17 - |
- |
19 |
5 |
Penicillium candidum |
7 |
10 |
14 - |
- |
31 |
6 |
Trichoderma viridae |
- |
- |
2 - |
- |
2 |
Tabel 1 di atas menunjukkan bahwa dari enam jenis jamur yang teridentifikasi pada penelitian ini, Aspergillus flavus terlihat paling mendominasi. Hal ini mendasari
penulis untuk melakukan uji daya hambat pada ekstrak bahan alam menggunakan daun kaliandra (Calliandra calothyrsus Meissn.) pada jamur uji Aspergillus flavus.

Gambar 7. Uji aktivitas daya hambat ekstrak kasar daun kaliandra pada konsentrasi 100.000 ppm dan 10.000 ppm terhadap pertumbuhan jamur Aspergillus flavus
T
Tabel 2. Diameter daya hambat ekstrak kasar daun kaliandra terhadap pertumbuhan jamur Aspergillus flavus
Perlakuan (ppm) |
Zona Bening (mm) |
0 |
0.00 ± 0.00a |
100 |
0.00 ± 0.00a |
1.000 |
0.00 ± 0.00a |
10.000 |
0.00 ± 0.00a |
100.000 |
12,72 ± 0.27b |
Keterangan : bila nilai pada kolom yang tertera pada Tabel 2 di atas diikuti oleh notasi huruf yang sama, maka nilai yang diperoleh dari perlakuan tersebut tidak berbeda nyata pada taraf uji 0,05% (P<0,05)
PEMBAHASAN
Tabel dua menunjukkan bahwa uji ekstrak kasar daun kaliandra pada konsentrasi 100 ppm, 1.000 ppm, 10.000 ppm dan kontrol (methanol) tidak dapat menghambat pertumbuhan jamur Aspergillus flavus. Perlakuan dengan konsentrasi uji 100.000 ppm, pertumbuhan jamur kontaminan Aspergillus flavus dapat dihambat dengan zona hambat rata-rata yang dihasilkan sebesar 12,72 mm (P≤0,05) dan berbeda nyata dengan kontrol. Hal tersebut menunjukkan bahwa kenaikan konsentrasi ekstrak kasar daun kaliandra dapat menghambat pertumbuhan koloni jamur Aspergillus flavus pada media Potato Dextrose Agar (Gambar 7).
Perbedaan diameter zona hambat ini disebabkan oleh adanya perbedaan konsentrasi senyawa aktif dalam hal ini senyawa metabolit sekunder yang terkandung pada daun kaliandra tersebut. Presscot (2005), menyatakan bahwa ukuran dari zona hambat dipengaruhi oleh media kultur dan kondisi inkubasi, kecepatan difusi dari senyawa metabolit sekunder tersebut dan konsentrasi dari senyawa metabolit sekunder dan tingkat sensitivitas dari organisme yang diujikan.
Aktivitas daya hambat dari ekstrak kasar daun kaliandra terhadap Aspergillus flavus menunjukkan bahwa tanaman kaliandra mempunyai potensi sebagai fungisida nabati. Namun, penelitian tentang aktivitas antijamur dari tanaman kaliandra masih belum banyak dilakukan dan dipublikasikan hanya beberapa penelitian yang diperoleh penulis seperti penelitian dari Tangenjaya dan Nurahmadhan. Menurut Tangenjaya (1992), sifat tanin yang
terdapat pada daun kaliandra memiliki sifat anti hama sehingga dapat mencegah serangan serangga dan jamur. Nurahmadhan (2010), menjelaskan komposisi kandungan daun kaliandra yaitu, secara kimiawi daun kaliandra mengandung protein berkisar 20%, terdapat tanin 8 - 11%, saponin, glikosida dan flavonoid dan dalam jumlah kecil yang tidak membahayakan ternak. Wina dkk., (2000), menyatakan bahwa kandungan tanin yang terdapat pada kaliandra merupakan salah satu yang tertinggi dibandingkan dengan daun legume yang lain yang sudah dikenal peternak seperti gamal dan lamtoro. Tanin merupakan senyawa fenolik yang mengandung protein dengan berat molekul cukup tinggi yang mengandung gugus hidroksil dan kelompok lain yang cocok (seperti karboksil) untuk membentuk kompleks senyawa yang efektif dengan protein dan makro molekul (Enny, 2007). Tanin merupakan suatu senyawa growth inhibitor yang dapat menghambat pertumbuhan mikroorganisme dan dapat menyebabkan enzim yang dihasilkan oleh mikroorganisme menjadi tidak reaktif (Arpini, 2007).
Penelitian yang telah dilakukan oleh Sulistyawati dan Mulyati (2009), melaporkan bahwa daun jambu mete (Anacardium occidentale, L) memiliki efek antijamur karena mengandung senyawa kimia antara lain tanin, senyawa fenol, flavonol, asam eleganat, asam anakardiol, kardol dan matal kardol. Senyawa kimia yang paling berperan sebagai antijamur yaitu fenol dan tanin. Hal ini dikarenakan di dalam daun jambu mete terdapat kandungan tanin dan fenol yang berfungsi sebagai antijamur. Dengan demikian semakin tinggi konsentrasi ekstrak kasar daun jambu mete
ΓΛΓΛ Λ I Directoryof OPEN ACCESS
L√kJΛΛ⅛J JOURNALS
maka akan semakin rendah pertumbuhan C. albicans yang menempel pada plat akrilik. Semakin tinggi konsentrasi ekstrak kasar daun jambu mete yang digunakan maka kandungan fenol dan tanin yang berfungsi sebagai antijamur utama juga semakin banyak sehingga daya hambat terhadap pertumbuhan C. albicans juga semakin besar. Hal ini didukung oleh penelitian Paaver et al. (2010), yang menyatakan bahwa tanin mempunyai efektivitas dalam menghambat pertumbuhan C. albicans. Selain itu ditambahkan dalam penelitian Nurhanafi et al. (2012), bahwa daun kelor (Moringa oleifera Lamk.) mengandung tanin, saponin dan senyawa flavonoid yang mempunyai efek sebagai antijamur dan antibakteri.
Berdasarkan tiga contoh hasil penelitian terkait di atas dapat disimpulkan bahwa yang berperan sebagai antijamur adalah senyawa metabolit sekunder diantaranya tanin, saponin dan flavonoid. Tanaman kaliandara memiliki komposisi tanin yang cukup tinggi, yaitu 8 - 11 %. Kesamaan hasil penelitian ini didasarkan pada kandungan senyawa tanin yang dapat menghambat sejumlah spesies jamur berbahaya. Secara in vitro beberapa jenis jamur kontaminan dapat dihambat oleh senyawa tanin yang terdapat pada berbagai tumbuhan, khususnya tanaman kaliandra.
Mekanisme penghambatan pertumbuhan jamur dari ekstrak kasar daun kaliandra pada jamur uji Aspergillus flavus berasal dari senyawa metabolit sekunder. Senyawa tanin dan flavonoid yang terkandung dalam ekstrak kasar daun kaliandra termasuk golongan senyawa fenolik. Senyawa fenolik dan saponin bersifat mudah larut dalam air (Manitto, 1992). Menurut Parwata dan Dewi (2008), senyawa fenolik mengandung gugus fungsi hidroksil (-OH) sehingga lebih mudah masuk ke dalam sel dan membentuk kompleks dengan protein membran sel. Senyawa fenolik berinteraksi dengan protein membran sel melalui proses adsorpsi yang menyertakan ikatan hidrogen dengan cara terikat pada bagian hidrofilik dari membran sel. Kompleks protein dengan senyawa yang berikatan lemah akan mengalami peruraian kemudian diikuti penetrasi senyawa fenolik ke dalam membran sel yang menyebabkan
KEPUSTAKAAN
Achmadi, J. 1998. Pengaruh Jamur Kapang Pada Ternak.
Jurusan Teknologi Pangan dan Gizi Fakultas Pertanian Institut Pertanian Bogor. Bogor.
Arpini, P.A. 2007. Daya Hambat Ekstrak Kayu Siwak (Salvadora persica L.) Terhadap pertumbuhan Bakteri dan Jamur yang Diisolasi dari Gigi. Jurusan Biologi Fakultas Matematika
dan Ilmu Pengetahuan Alam Universitas
Udayana. Skripsi S-1. Tidak Dipublikasikan, Jimbaran.
Deptan. 2012. Pedoman Umum Pengembangan Lumbung Pakan Unggas. Direktorat Jenderal Peternakan dan Kesehatan Hewan Kementerian
Pertanian. Jakarta.
Enny, K.A. 2007. Pengaruh Kecepatan Putar Pengadukan dan Suhu Operasi pada Ekstraksi Tanin Dari Jambu Mete Dengan Pelarut Aseton. Jurusan Teknik Kimia Fakultas Teknik Universitas Sebelas Maret. Surakarta.
Gandjar, I., R.A. Samson, K.T. Vermeulen, A. Oetari. I. Santoso. 1999. Pengenalan Kapang Tropik Umum. Yayasan Obor Indonesia. Jakarta.
Handayani, S., dan Sulistyo, J. 2000. Analisis Keragaman Kapang Pencemar Pakan Unggas Komersial. Jurnal Mikrobiologi Indonesia : Balitbang Mikrobiologi, Puslitbang Biologi Lembaga
Ilmu Pengetahuan Indonesia. Bogor.
Hastiono, S. 1983. Peranan Mikotoksin Dalam Industri Makanan Ternak. Bogor.
Huang, Y.W., Chung, K.T., Wang, T.Y., Wei Ci., Lin Y.
1998. Tanins and Human Health. Food Science Nutrition Journal.
presipitasi dan terdenaturasinya protein membran sel. Kerusakan pada membran sel menyebabkan perubahan permeabilitas pada membran sel, sehingga mengakibatkan hancurnya membran sel jamur.
Tanin adalah senyawa yang bersifat lipofilik sehingga mudah terikat dan mengakibatkan kerusakan pada dinding sel. Selain itu, tanin juga dapat menghambat sintesis khitin yang merupakan komponen utama dinding sel jamur (Huang et al., 1998; Nuraini, 2002; Naim, 2004).
Mekanisme lain yang diduga dapat menyebabkan pertumbuhan jamur kontaminan terhambat adalah terjadinya penghambatan sintesis asam nukleat dan protein; dan penghambatan fase mitosis sel jamur. Telah diketahui bahwa DNA, RNA dan protein memegang peranan penting di dalam proses kehidupan normal sel, sehingga gangguan yang terjadi pada proses pembentukan atau fungsi zat-zat tersebut dapat mengakibatkan kerusakan total pada sel secara keseluruhan. Senyawa antijamur dapat menghambat sintesis protein dengan cara menghalangi terikatnya RNA pada tempat spesifik di ribosom selama proses pemanjangan rantai peptida sehingga sintesis asam nukleat dan protein menjadi terhambat. Efek antijamur ekstrak kemungkinan juga mampu mengikat protein mikrotubuli (sitoskeleton) dalam sel, kemudian merusak struktur spindle mitotic dan menghentikan metafase pembelahan sel jamur (Pelczar dan Chan, 1996).
SIMPULAN
(1). Diperoleh 6 (enam) jenis jamur kontaminan pada pakan konsentrat ayam ras pedaging meliputi: Aspergilus flavus, Aspergillus niger, Aspergillus fumigatus, Penicillium brevicompactum, Penicillium candidum dan Trichoderma viridae. (2). Daun kaliandra memiliki kemampuan untuk menghambat pertumbuhan jamur Aspergillus flavus yang mengkontaminasi pakan konsentrat ayam ras pedaging. (3). Konsentrasi ekstrak kasar daun kaliandra 100.000 ppm dapat menghambat pertumbuhan jamur Aspergillus flavus dengan zona hambat rata-rata yang dihasilkan sebesar 12,72 ± 0,27 mm.
Infomedion. 2011. Persoalan Jamur dan Mikotoksin pada Ransum.
Available at :
ransum?tmpl=component&print=1&page=
Opened : 29/07/2013
Infovet. 2008. Musim Penghujan, Pakan dan Ayam Kerdil.
Available at :
http://www.majalahinfovet.com/2008/01/musim-penghujan-pakan-dan-ayam-kerdil.html
Opened : 12/08/2013
Infovet. 2010. Persoalan Mikotoksin Pada Pakan.
Available at :
http://pkppullet.com/2010/01/persoalan-mikotoxin-pada-pakan.html
Opened : 29/07/2013
Manitto, P. 1992. Biosintesis Produk Alami. IKIP Press. Semarang.
Mannetje, L.T. dan R.M. Jones. 1992. Plant Resources of South East Asia No.4 Forrages. Penerbit Prosea. Bogor.
Marquerita, L., Setyowati dan Gunawan. 1990. Kasus Aspergillus Pada Ayam Buras. Buletin BPPH No. 6. Naim, R. 2004. Senyawa Antimikroba Dari Tanaman.
Available at :
http://kompas.com/kompascetak/0409/15/sorotan/12 65264.htm
Opened : 6/12/2015
Najib, A. 2009. Tanin.
Available at :
http://nadjeeb.files.wordpress.com/2009/03/tanin.pdf
Directoryof OPEN ACCESS JOURNALS
Opened : 6/12/2015
Nurahmadhan. 2010. Leguminosa.
Available at :
http://nurahmadhan.com/2010/01/ leguminosa.html Opened : 29/07/2013
Nuraini, F., Rizal, S., Yudiantoro. 2008. Pengaruh Konsentrasi Kitosan Terhadap Aktivitas Antibakteri Dengan Metode Difusi Agar (Sumur). Jurusan Teknologi Hasil Pertanian Fakultas Pertanian
Universitas Lampung. Bandar Lampung.
Nurhanafi, F., Muwarni, S., dan Winarso, D., 2012. Perbandingan Potensi Antimikroba Ekstrak n-Heksana Daun Kelor (Moringa oleifera) dengan Kulit Biji (Pericarp) Jambu Mete (Anacrdium occidentale) Terhadap Bakteri Pseudomonas aeruginosa secara in Vitro. Skripsi, Program Studi
Kedokteran Hewan, Universitas
Brawijaya.
Parwata, O.A dan Dewi, P.S. 2008. Isolasi dan Uji Aktivitas Antibakteri Minyak Atsiri dari Rimpang
Lengkuas (Alpina galanga L.). Jurnal Fak. MIPA. Jur. Kimia Universitas Udayana. Bukit, Jimbaran.
Paveer, U., Matto, V., and Real, A. 2010. Total Tannin Content in Distinct Quercus Robur L. galls. Journal of Medicinal Plants Research.
Pelczar dan Chan. 1994. Dasar-Dasar Mikrobiologi. Universitas Indonesia. Jakarta.
Pitt, J.I., and A.D. Hocking. 1997. Fungi and Food Spoilage. Ed ke-2. Blackie Academic and Professional. London.
Prescott, L.M. 2005. Microbiology. Edisi ke-6. Mc.Graw-Hill. USA. New York.
Proborini, M.W. 2002. Penuntun Praktikum Mikologi. Laboratorium Taksonomi Tumbuhan dan Mikologi. Jurusan Biologi Fakultas Matematika dan Ilmu Pengetahuan Alam Universitas Udayana. Bukit Jimbaran. Tidak Dipublikasikan.
Ritonga, H. 2008. Bahaya Racun Jamur Pada Ternak. Available at : http://technicalservice.com/2008/05/11/mycotoxin/ Opened : 12/08/2013
Smith, A.H., E. Zoetendal, and R.I. Mackie. 2005. Bacterial Mechanisms To Overcome Inhibitory Effects Of Dietary Tannins. Microb Ecol. New York.
Sulistyawati, D. dan Mulyati, S. 2009. Uji Aktivitas Antijamur Infusa Daun Jambu Mete
(Anacardium occidentale, l) Terhadap Candida albicans. Fakultas Biologi, Universitas setia Budi. Surakarta.
Tim Laboratorium INTP Fapet IPB. 2007. Pengetahuan Bahan Makanan Ternak. Fakultas Peternakan
Institut Pertanan Bogor. Bogor.
Tunjung, S.U., Y. Ramona, dan I.G. Rimaya. 2001. Daya Hambat Minyak Atsiri Sirih (Piper betle L.), Kunyit (Curcuma domestica Val.) dan Bawang Putih (Alium sativum) Pada Biakan Candida albicans. Jurusan Biologi FMIPA Unud. Jurnal Biologi Vol. 5 (1).
Wina, E., B. Tangendjaja, T. Ibrahim and B. Palmer. 1992. Kaliandra (Calliandra calothyrsus Meissn.) dan Pemanfaatanya. Balai Penelitian Ternak dan The Australian Center for International Agricultural Research (ACIAR).
36
Discussion and feedback